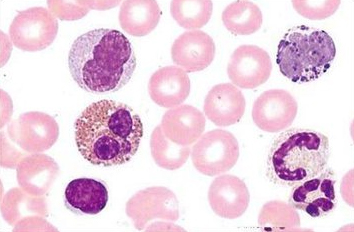
1494468855222376oYA1.jpg 6.jpg

近期,來自歐洲癌癥協(xié)會(huì)的一項(xiàng)研究顯示,白細(xì)胞計(jì)數(shù)可以預(yù)測免疫療法對(duì)肺癌患者的作用,免疫站點(diǎn)抑制劑雖然可以提高肺癌患者的整體生存率,但是并不是所有的非小細(xì)胞肺癌患者都能受益。因此,研究人員一直在尋找預(yù)測性的生物標(biāo)記物,來判斷哪些患者適用于免疫療法,以避免不必要的毒性和資源的浪費(fèi)。
研究人員表示:“腫瘤組織活檢時(shí),PD-L1的表達(dá)通常被用于確認(rèn)患者是否適用于免疫療法,但是有的時(shí)候這一結(jié)果并不準(zhǔn)確,因?yàn)樗鼰o法反應(yīng)不斷進(jìn)化的免疫反應(yīng),血液中的生物標(biāo)記物更易獲得,可能成為免疫反應(yīng)更好的表達(dá)者。”
此次研究的參與者為54名非小細(xì)胞肺癌患者,在接受免疫療法之前,兩周后,以及四周后分別進(jìn)行白細(xì)胞計(jì)數(shù),研究人員比較了對(duì)免疫療法有反應(yīng)和無反應(yīng)的患者白細(xì)胞數(shù)量。
研究人員表示:“自然殺傷細(xì)胞的數(shù)量和功能以及CD8+T細(xì)胞中PD-L1的頻繁表達(dá)是預(yù)測免疫療法對(duì)非小細(xì)胞晚期患者效果的有效途徑,兩種方法相輔相成可以使我們更加準(zhǔn)確的預(yù)測出患者是否適用于免疫療法進(jìn)行治療?!?/p>
“現(xiàn)代精準(zhǔn)醫(yī)學(xué)需要我們?yōu)槊恳晃换颊哒业阶钸m合他們的治療方案,這樣做不但節(jié)約了醫(yī)療成本,也可以使患者免受無妄之災(zāi)?!?/p>
浙公網(wǎng)安備33010802007965號(hào)